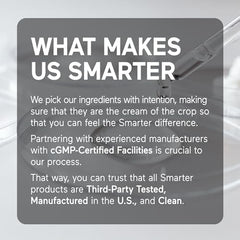
Nutrition facts label for Smarter Magnesium Complex

Smarter Nutrition Magnesium Complex | Chelated Glycinate + Citrate
- $221.90
- $221.90
- Unit price
- per
Free Shipping
We offer free standard shipping to every province and territory in Canada.
Free Returns
Seasonal Shipping Delays to Outer Regions
Description
xSmarter Magnesium Complex blends four highly absorbed forms of magnesium—glycinate, citrate, malate, and marine-derived Aquamin—plus AlphaWave L-Theanine to support sleep, relaxation, and muscle & nerve function. Non-GMO, dairy- and wheat-free, manufactured in the USA in a cGMP-certified facility. 360 tablets, approximately a 180-day supply.
Shipping & Return
xReturn Policy
We accept returns within 30 days only in cases where the issue is caused by the seller. Eligible situations include:
• The package arrived damaged during shipping
• The item arrived damaged, defective, or different from what was ordered
• The product arrived with an expired or near-expired date
To be eligible for a return, your item must be in the same condition that you received it — unopened, unused, and in its original packaging. Proof of purchase through your Amazon order will be required.
To start a return, please contact us at canadianvit@gmail.com
Returns must be sent to the following address:
6 Shea Way, Newark, Delaware 19713, United States
If your return is accepted, we’ll send you a prepaid return shipping label along with detailed instructions on how and where to send your package.
Items sent back to us without prior authorization will not be accepted.
You can always reach out with any return-related questions at canadianvit@gmail.com
Damages and Issues
Please inspect your order upon arrival and contact us immediately if the item is damaged, defective, expired, or if you received the wrong item, so we can quickly assist you and make it right.
Exceptions / Non-Returnable Items
Certain types of products cannot be returned, such as:
-
Opened or partially used dietary supplements
-
Perishable goods (like food or beverages)
-
Custom or personalized items
-
Hazardous materials, flammable liquids, or gases
We also do not accept returns on sale items or gift cards.
If you’re unsure whether your item qualifies for a return, please contact us before sending it back.
Exchanges
The quickest way to get the item you want is to return the original one (if eligible), and once the return is approved, place a new order for the desired product.
European Union 14-Day Cooling-Off Period
If your order is shipped to the European Union, you have the right to cancel or return your purchase within 14 days, for any reason and without explanation.
As with our standard policy, the item must be in the same condition that you received it — unopened, unused, and in its original packaging, with proof of purchase.
Refunds
Once we receive and inspect your return, we’ll notify you about the approval status.
If approved, you’ll be automatically refunded to your original payment method within 10 business days.
Please note that it may take additional time for your bank or credit card company to process and post the refund.
If more than 15 business days have passed since we approved your return, please contact us at canadianvit@gmail.com
Shipping
All orders are processed within 2–3 business days after payment confirmation. Orders placed on weekends or holidays will be processed on the next business day.
If there is a delay in fulfilling your order, we will notify you promptly by email.
Shipping Time
We ship across all provinces and territories in Canada.
Standard delivery: up to 5 business days after dispatch in most regions.
Remote or northern regions: 6–10 business days due to distance, weather conditions, and limited carrier routes.
While we always strive for timely delivery, once a package has been handed over to the carrier, Canadian Glow is not responsible for carrier delays or weather-related disruptions.
Shipping Confirmation and Tracking
Once your order has shipped, you will receive a shipping confirmation email containing your tracking number and link. Tracking details typically become active within 24–48 hours after shipment.
Shipping Rates
Shipping within Canada is free on all orders. Expedited or express delivery options may be available at checkout for an additional fee depending on your location.
Address Accuracy
Please ensure your shipping address is complete and accurate before placing your order. Canadian Glow is not responsible for delays, lost shipments, or delivery issues caused by incorrect or incomplete addresses.
Damaged or Lost Packages
If your order arrives damaged, please contact us immediately at canadianglow.ca@gmail.com with photos of the package and its contents. We will assist you and resolve the issue as quickly as possible.
If your package is marked as “delivered” but you have not received it, please check with neighbours or your local delivery office. If the issue continues, email us — we will help you initiate a claim with the carrier.
International Shipping
At this time, we only ship within Canada. We may expand our shipping coverage to international destinations in the future.
Contact
If you have any questions about shipping, please contact us at:
📧 canadianglow.ca@gmail.com


